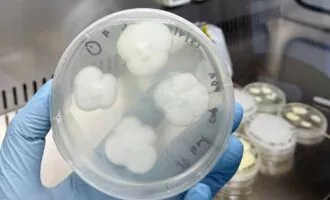
بازیافت

بازیافت
آخرین مطالب
-
اینترنت و شبکه خلاقیت در بازیافت؛ مهندس رومانیایی یک ویپ یکبارمصرف را به وب سرور تبدیل کرد
وب سرور این ویپ میتواند یک صفحه وب را در ۱۶۰ میلیثانیه بارگذاری کند.
![تبدیل ویپ یکبارمصرف به وب سرور]() ۲۷ شهریور ۱۴۰۴
۲۷ شهریور ۱۴۰۴
-
محیط زیست وسترن دیجیتال و مایکروسافت عناصر کمیاب هارد درایوها را بازیافت میکنند
وسترن دیجیتال با همکاری مایکروسافت طرح بازیافتی بزرگی را برای هارد دیسکهای غیرقابلاستفاده راهاندازی کرده است.
![بازیافت درایو وسترن دیجیتال]() ۲ اردیبهشت ۱۴۰۴
۲ اردیبهشت ۱۴۰۴
-
دیجیتک ۵ راهکار خلاقانه برای استفاده از دیوایسهای قدیمی
در این اپیزود از دیجیتک شما را با ۵ روش خلاقانه آشنا میکنم که از دیوایسهای قدیمی خود بهترین استفاده ممکن را بکنید
![دیوایس]() ۱۰ دی ۱۴۰۳
۱۰ دی ۱۴۰۳
-
محیط زیست دانشمندان ژاپنی پلاستیک سازگار با محیطزیست ساختهاند که در آب دریا حل میشود
این نوع جدید از پلاستیک میتواند مشکل آلوده شدن دریاها را حل کند.
![آلودگی پلاستیک]() ۶ دی ۱۴۰۳
۶ دی ۱۴۰۳
-
محیط زیست چگونه میتوان زبالههای پلاستیکی را به غذای قابل خوردن تبدیل کرد؟
سازمان دارپا بهدنبال سیستمی است که بتواند از ضایعات پلاستیکی سربازان در شرایط سخت، مکمل غذایی با ارزش تغذیهای بالا بهدست آورد.
![تبدیل ضایعات پلاستیک به غذا]() ۴ شهریور ۱۴۰۳
۴ شهریور ۱۴۰۳
-
محیط زیست دستاورد جدید دانشمندان: تبدیل تهسیگار به سوخت بیودیزل
دانشمندان لیتوانیایی ضایعات سیگار را برای تولید سوخت بیودیزل تغییر میدهند و هزینههای تولید کاهش مییابد.
![]() ۷ دی ۱۴۰۲
۷ دی ۱۴۰۲
-
کامپیوتر و سخت افزار دستاورد بزرگ محققان: ساخت برد مدار چاپی جدیدی که در آب حل میشود!
این PCB در برخورد با آب داغ قابل تجزیه است و با کمک آن میتوان تولید کربن و زبالههای الکترونیکی را کاهش داد.
![PCB قابل تجزیه در آب]() ۷ مرداد ۱۴۰۲
۷ مرداد ۱۴۰۲
-
محیط زیست محققان با نوعی قارچ پلاستیکخوار میخواهند مشکل بازیافت زبالههای پلاستیکی را برطرف کنند
محققان دانشگاه سیدنی با کمک نوعی قارچ معمولی، به روشی جدید برای بازیافت پلاستیک دست یافتهاند.
![بازیافت]() ۲۹ فروردین ۱۴۰۲
۲۹ فروردین ۱۴۰۲
-
محیط زیست ادامه برنامههای زیستمحیطی اپل: تمام باتریهای جدید اپل تا ۲۰۲۵ از کبالت بازیافتی ساخته میشوند
اپل میخواهد برای خنثیسازی ردپای کربنی و حفظ وجهه عمومی، استفاده از کبالت بازیافتی در باتریها را تا ۲۰۲۵ به صددرصد برساند.
![کبالت بازیافتی]() ۲۵ فروردین ۱۴۰۲
۲۵ فروردین ۱۴۰۲
-
علمی قطر 80 درصد زبالههای جام جهانی 2022 را بازیافت کرد
قطر میگوید موفق شده است تا بیش از 2000 تن از زبالههای جام جهانی 2022 را بازیافت یا به کود تبدیل کند.
![قطر 2022]() ۷ دی ۱۴۰۱
۷ دی ۱۴۰۱
-
علمی گام دیگری در حفاظت از محیطزیست: دانشمندان روش جدیدی برای بازیافت پلاستیک توسعه دادند
دانشمندان مؤسسه بازیافت پلاستیک (iCOUP) در وزارت انرژی ایالات متحده (DOE) روش جدیدی را برای بازیافت پلی اتیلن با چگالی بالا (HDPE) توسعه دادهاند. دانشمندان ...
![HDPE]() ۶ دی ۱۴۰۱
۶ دی ۱۴۰۱
-
علمی محققان روش جدیدی برای بازیافت پلاستیک بدون تولید آلودگی ابداع کردند
دانشمندان در این روش زبالههای پلاستیکی را به اجزای مولکولی آنها تجزیه میکنند و میتوانند با استفاده از این مواد، محصولات جدید بسازند.
![زبالههای پلاستیکی]() ۲۵ آذر ۱۴۰۱
۲۵ آذر ۱۴۰۱
-
علمی طلای بازیافتشده از سیمکارتها میتواند برای ساخت دارو استفاده شود
محققان از طلای بازیافتی سیمکارت، بهعنوان کاتالیزوری برای واکنشهای شیمیایی مورد استفاده در ساخت دارو، استفاده کردند.
![سیم کارت]() ۲۱ آذر ۱۴۰۱
۲۱ آذر ۱۴۰۱
-
علمی درسهایی از طبیعت؛ وارد کردن دوباره پسماند به چرخه
یکی از آثاری که تا سالها پس از عمر اکثر افرادی که از همهگیری جان سالم به در بردهایم، در طبیعت میماند، پسماندهای آن است.
![بازیافت پلاستیک]() ۱۴ مهر ۱۴۰۱
۱۴ مهر ۱۴۰۱
-
علمی دانشمندان میخواهند نسل بعدی پرههای توربینهای بادی را به صورت آبنبات بازیافت کنند
محققان موفق به ساخت مادهای شدهاند که برای استفاده در تولید توربینهای بادی کاربرد دارد و سپس میتواند به محصولاتی مثل آبنبات تبدیل شود.
![]() ۲ شهریور ۱۴۰۱
۲ شهریور ۱۴۰۱
-
علمی ابرکرمهای پلاستیکخوار؛ راهکاری جدید برای بازیافت زبالهها
تحقیقات جدید نشان داده که معده یک نوع کرم خاص دارای آنزیمهایی است که میتوانند پلاستیک را تجزیه کنند. دانشمندان حالا امیدوارند بتوانند از این ...
![ابرکرمهای پلاستیکخوار]() ۲۲ خرداد ۱۴۰۱
۲۲ خرداد ۱۴۰۱
-
اخبار خودرو روش جدید تولید فیبرکربن ابداع شد؛ ارزان تر و سبز تر برای خودروهای آینده
فیبرکربن یکی از اصلی ترین مواد در صنایع مختلف و به خصوص در صنعت خودروسازی است. این ماده که وزن سبک با ساختار بسیار مقاوم ...
![روش جدید تولید فیبرکربن]() ۱ بهمن ۱۴۰۰
۱ بهمن ۱۴۰۰
-
علمی اولین مدال طلای المپیک ۲۰۲۰ توکیو ساخته شده از لوازم الکترونیکی بازیافتی اهدا شد
«کیان یانگ» تیرانداز چینی در ماده تفنگ بادی ۱۰ متر زنان بازیهای المپیک ۲۰۲۰ توکیو اولین مدال طلای این مسابقات که به صورت کامل از ...
![]() ۲ مرداد ۱۴۰۰
۲ مرداد ۱۴۰۰
-
تکنولوژی انبارهای آمازون سالانه میلیونها محصول فروخته نشده را از بین میبرند
آمازون سالانه میلیونها محصول فروخته نشده را که در انبارهای این شرکت باقی میمانند، معدوم میکند و حالا گزارشی از یکی از انبارهای این شرکت ...
![]() ۱ تیر ۱۴۰۰
۱ تیر ۱۴۰۰
-
تکنولوژی طرح جدید سامسونگ موبایلهای قدیمی گلکسی را به لوازم IoT تبدیل میکند
سامسونگ از گسترش برنامه استفاده مجدد از گوشیهای قدیمی گلکسی موسوم به Galaxy Upcycling خبر داد که امکان تبدیل آنها به لوازم اینترنت اشیا را ...
![]() ۲۲ دی ۱۳۹۹
۲۲ دی ۱۳۹۹

همچنین میتوانید جهت آگاهی از آخرین اخبار در حوزه تکنولوژی و اطلاع از بروزرسانی دیجیاتو مارا در شبکههای اجتماعی زیر نیز دنبال کنید. خوشحالیم که همراه ما هستید.